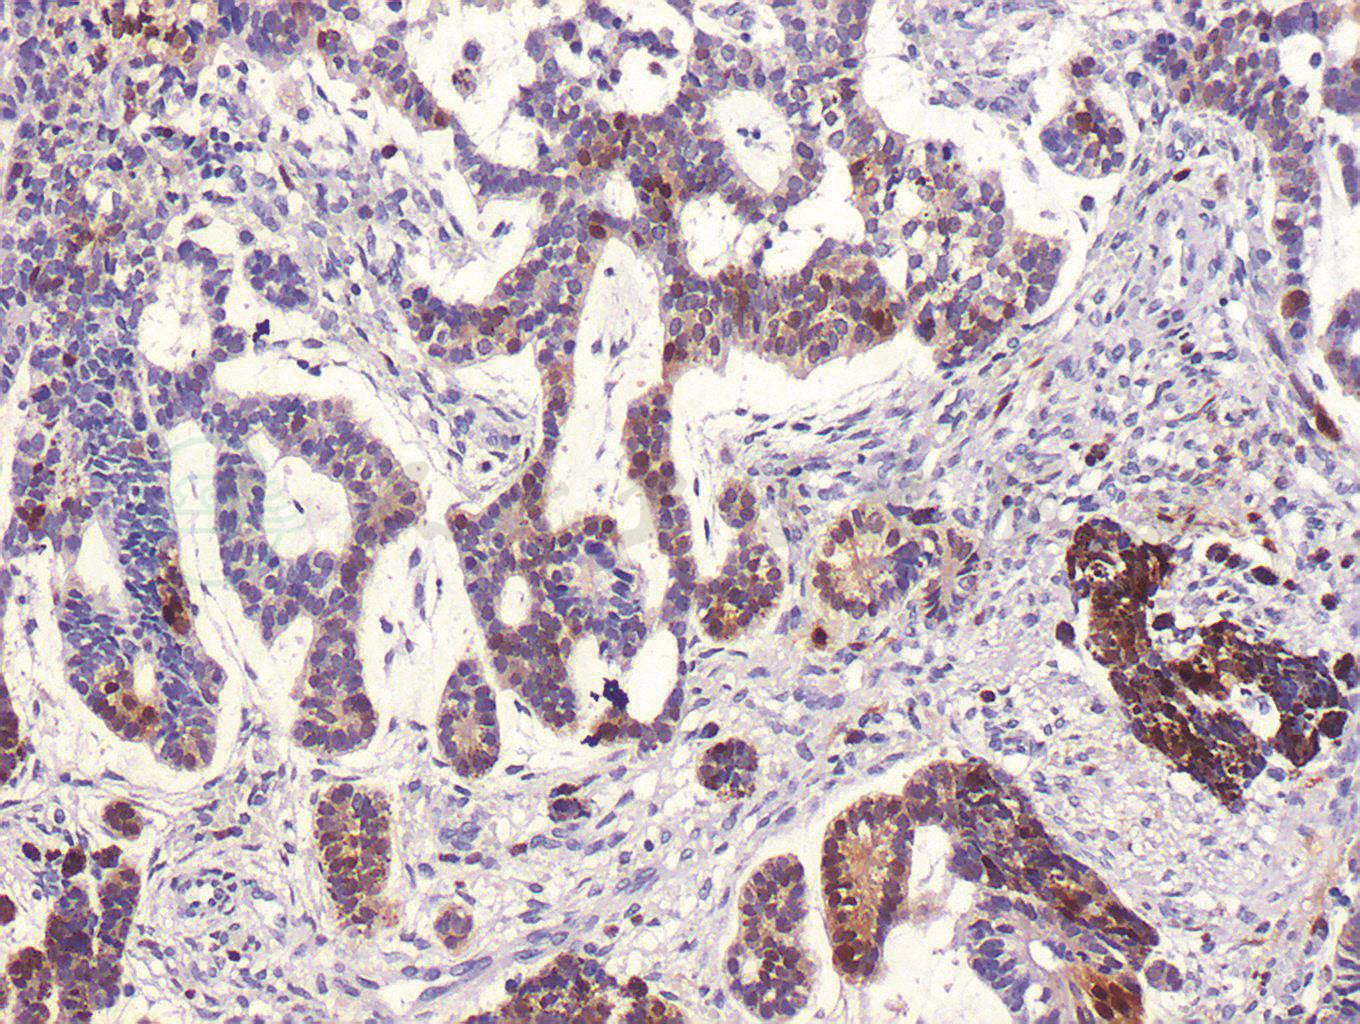

刘骁、马建民
髓上皮瘤是一种罕见的起源于原始视杯的内层髓上皮细胞的肿瘤,根据肿瘤组织组成的成分不同分为畸胎瘤样髓上皮瘤和非畸胎瘤样髓上皮瘤两类,发生于眼内的畸胎瘤样髓上皮瘤极为罕见。
2.5岁男童因左眼外伤1个月,曾就诊于当地医院,诊断为左眼前房积血,行眼部B型超声和眼眶CT检查后发现左眼球内占位性病变,提示视网膜母细胞瘤可能性大,建议转我院就诊。我院眼科检查显示:左眼混合充血,角膜水肿混浊,前房积血,眼内窥不清,左眼外斜视。经综合评估后,建议患儿行左眼球摘除术联合一期义眼台植入术,术后行病理组织学检查最终结果显示为左眼畸胎瘤样髓上皮瘤。患儿密切随访至今,病情稳定。
儿童;眼内肿瘤;钙化;畸胎瘤样髓上皮瘤
患儿男性,2.5岁,因发现左眼球内占位1个月就诊于首都医科大学附属北京同仁医院眼肿瘤科。患儿父母主述患儿1个月前玩耍时不慎碰伤左眼,就诊于当地医院,诊断为左眼前房积血,行眼部B型超声和眼眶CT检查后发现左眼球内占位性病变,提示视网膜母细胞瘤可能性大,故建议转诊首都医科大学附属北京同仁医院诊治。患儿既往身体健康,足月顺产,否认吸氧史及其他病史,否认家族遗传病史。患儿全身一般情况良好。眼部检查:双眼视力检查不合作,右眼眼压Tn,左眼T-1,左眼混合充血,角膜水肿、混浊,前房积血,眼内窥不清,左眼外斜视15△,眼球运动正常。右眼检查未见明显异常。本院眼部医学影像学检查结果:B型超声检查显示左眼眼轴较右侧缩短,左眼球内实性占位病变,不能排除视网膜母细胞瘤。CT扫描显示左侧眼球内高密度影并可疑性软组织影,外伤后出血机化可能性大,不能排除恶性病变可能(图1)。MRI扫描显示左侧眼球晶状体-虹膜-睫状体区占位性病变的可能性大,外伤后出血机化,形成增生性组织,恶性肿瘤待排除(图2)。血常规、尿常规及生化指标的实验室检查均未发现异常。
该病例的特点有:患儿2.5岁,年龄小;有外伤史;左眼混合充血,角膜水肿混浊、前房积血、左眼外斜视;B超示左眼球内实性占位,左眼轴较右眼短,提示左眼已经发生眼球萎缩,说明病史较长,病情较重;CT示左眼球内实性占位,可见钙化斑,如果没有外伤史,此种改变基本可以诊断为视网膜母细胞瘤;MRI示左眼病变累及部位为晶状体-虹膜-睫状体区域,而此区域却不是视网膜母细胞瘤发生的常见区域。

图1 眼眶CT扫描影像结果
A.水平位,B.冠状位,显示左眼内肿物位于眼球前部,肿物内可见高密度钙化影。
引自:主编:.同仁眼科疑难病例精析:同仁眼科临床病例讨论会1.第1版.ISBN:978-7-117-33030-5

图2 眼眶MRI扫描影像结果
A.T1水平位,B.T2水平位,C.T1矢状位,D.增强水平位,显示左眼虹膜睫状体区可见实性占位性病变,增强扫描后可见肿瘤明显增强。
引自:主编:.同仁眼科疑难病例精析:同仁眼科临床病例讨论会1.第1版.ISBN:978-7-117-33030-5
初步诊断:左眼视网膜母细胞瘤、左眼球萎缩、左眼废用性外斜视。综合评估患儿病情后,建议行左眼球摘除联合病理组织学检查,以明确诊断。患儿家属同意后在全身麻醉下行左眼眼球摘除联合一期义眼台植入术。手术顺利,术后恢复好。
术后病理组织学检查结果显示左眼畸胎瘤样髓上皮瘤,肿瘤细胞生长活跃(图3)。肿瘤主要位于虹膜后的前玻璃体腔,视盘、筛板、筛板后视神经及视神经切除断端均未见明显肿瘤组织侵犯,肿瘤组织附近可见虹膜、睫状体色素上皮呈瘤样增生,并见软骨组织和纤维结缔组织增生,虹膜表面机化膜形成,虹膜周边粘连,继发视网膜脱离及视网膜下可见渗出。肿瘤组织行免疫组织化学染色检测显示:S-100(+),CD56(+),NSE(-),Syn(-),GFAP(-),Vimentin(-),Ki-67(-),Bcl-2(-),Melan-A(-),HMB45(+)(图4)。最终诊断为左眼畸胎瘤样髓上皮瘤。患儿术后1周出院,建议到儿科会诊,密切随访至今,病情稳定未见复发(图5)。

图3 左眼畸胎瘤样髓上皮瘤组织病理学检测(HE,100×)
引自:主编:.同仁眼科疑难病例精析:同仁眼科临床病例讨论会1.第1版.ISBN:978-7-117-33030-5
图4 左眼畸胎瘤样髓上皮瘤免疫组织化学染色S-100阳性(DAB,100×)
引自:主编:.同仁眼科疑难病例精析:同仁眼科临床病例讨论会1.第1版.ISBN:978-7-117-33030-5

图5 患儿半年后复查照片
引自:主编:.同仁眼科疑难病例精析:同仁眼科临床病例讨论会1.第1版.ISBN:978-7-117-33030-5
临床表现
髓上皮瘤又称神经上皮瘤(neuroepithelioma)或视网膜胚瘤(diktyoma),是起源于原始视杯内层髓上皮细胞的一种罕见的肿瘤,而虹膜后色素上皮和睫状体无色素上皮起源于视杯内层细胞(即原始髓上皮),故肿瘤主要发生于睫状体区,少数病例发生于原始髓上皮细胞分布的其他部位,如虹膜后表面、视网膜或视神经。根据肿瘤组织组成成分不同可将髓上皮瘤分为非畸胎瘤样髓上皮瘤和畸胎瘤样髓上皮瘤两类,前者瘤体由巢状或片状的低分化神经上皮细胞和原纤维状基质组成;后者瘤体内除此以外还可见软骨或骨骼肌组织。
髓上皮瘤的发病年龄较小,一般在5岁以内。该病多为单眼发病,极少有双眼发病者。眼内髓上皮瘤常以白瞳症、斜视、视力下降或眼痛就诊,因肿瘤常发生在睫状体区域,易继发青光眼。新生睫状体假膜是髓上皮瘤的特征性表现。这层假膜是由肿瘤细胞移行于晶状体后表面产生的一层胶原组织构成。MRI及UBM对诊断该病有一定的价值。髓上皮瘤的临床表现与视网膜母细胞瘤相类似,两者的鉴别诊断较为困难,导致病理诊断是鉴别两者的金标准。本例患儿的病理特征为肿瘤细胞生长活跃,肿瘤组织免疫组织化学检测S-100阳性。S-100为神经组织标志物,存在于神经组织,垂体、颈动脉体,肾上腺髓质、唾液腺、少数间叶组织内,常用于神经鞘瘤、恶性黑色素瘤、脂肪肉瘤、软骨肿瘤诊断等。结合病理组织学改变和免疫染色结果,本例患儿最终诊断为畸胎瘤样髓上皮瘤。
大多数视网膜母细胞瘤患者的最大特点包括发病年龄小、眼球内实性占位、CT扫描可见眼球内钙化斑出现。如果髓上皮瘤发生在眼内,眼眶CT和MRI扫描可见眼球内实性占位性病变,且CT扫描还显示眼球内有钙化斑点,此时极易误诊为视网膜母细胞瘤。本例髓上皮瘤患儿CT扫描结果显示眼内出现具有钙化斑样实性占位,且患儿年龄2.5岁,故初诊时高度怀疑为视网膜母细胞瘤,后经病理组织学检查证实为畸胎瘤样髓上皮瘤,才得以确诊。
治疗方案
鉴于畸胎瘤样髓上皮瘤局部切除时易残留肿瘤细胞,且考虑本例患儿已发生眼球萎缩,故综合评估患儿病情后,建议行眼球摘除术联合一期义眼台植入术。通过手术不仅可以确保肿瘤的彻底切除,同时行病理组织学检查可以明确诊断,而且眼球摘除联合一期义眼台植入,可以使患儿手术后眼眶大致得以正常发育。如果发生肿瘤蔓延到眼球外者需行眶内容物摘除术,手术后根据具体病情辅以放射疗法或化学疗法。因该病罕见,其确切预后尚待观察,故患儿术后需要长期随访。
通过对该病例的学习我们应该了解到,对于儿童眼内钙化性病变我们不能单纯考虑视网膜母细胞瘤这种常见的有钙化性改变的疾病,而是应该发散思维、敢于思考、开阔眼界,全方面考虑各种疾病的可能性,通过对各种疾病的特征性表现的学习和积累来提高临床诊断水平。
[1]孙为荣.眼科病理学.北京:人民卫生出版社,1997:298-300.
[2]FONT RL,RISHI K.Diffuse retinal involvement in malignant nonteratoid medulloepithelioma of ciliary body in an adult. Arch Ophthalmol,2005,123 (8):1136-1138.
[3]宋国祥.眼眶病学.北京:人民卫生出版社,1999:227.
[4]杨振中,谢群.睫状体髓上皮瘤一例.中华病理学杂志,2002,31(6):521.
[5]SHIELD JA,EAGLE RC JR,SHIELD CL,et al.Congenital neoplasms of the nonpigmented ciliary epithelium. Ophthalmology,1996,03(12):1998-2006.
[6]SINGH A.Iris neovascularization in children as a manifestation of underlying medullopithelioma.J Pediatr OphthalmolStrabismus,2001,38(4):224-228.













